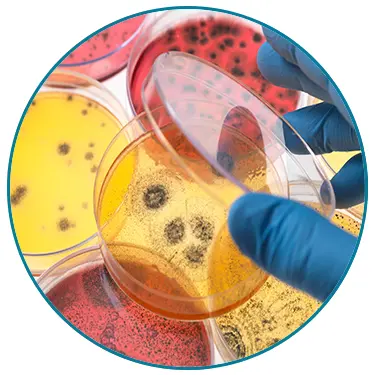

Siemens Sysmex CA-660
In Stock
Product code: Siemens-Sysmex-CA-660
Manufacturer: Siemens Healthineers
Shipping Weight: 95.00lbs (43.09kg)
WHY CHOOSE BLOCK SCIENTIFIC?
See why in 2 mins.
Siemens Sysmex CA-660
A sentence that’s music to every modern lab manager's ears.
Some labs need routine testing. Others need routine and specialty testing. The Siemens Sysmex CA 660 is an economical legacy testing solution that can be tailored to your lab’s specific needs. It’s easy to learn and maintain.
It offers…
Clotting
Chromogenic

Immunologic Testing
…for laboratories that need a broader test menu, speciality testing, and a value price. The sort of thing that doesn't tear your capital equipment budget to shreds.
Are we speaking your language yet?
Get more value from every sample
The Siemens Sysmex CA 660 helps blood labs get more value from every sample. And it helps make lab technicians jobs less stressful, so they don't hunt for work elsewhere.

So easy to use
This system is so easy to use (and learn!) that costly, speciality training is not required. Maximize your personnel time, and ensure your workflow is as efficient as possible!

Streamlines ordering
Save time through streamlined ordering and maintenance, with standardized reagents at a cost around 10-15% lower than you currently pay.

Reduce hands-on time (and just walk away)
The automated probe rinse eliminates tedious manual steps, while the simultaneous analysis of results frees up valuable time. The handheld, two-dimensional barcode reader makes data entry for ISI, control, and calibrator values, lot numbers, as easy as your more expensive primary analyzers.

Keep patient records safe
The sample barcode reader simplifies sample ID processing, so you can maintain the workflow you've developed with your primary analyzers.

Standardized results
Consistently monitor your patients from lab to lab. All Siemens systems are backward compatible, so you can integrate this easily with your newer analyzers.

It’s low maintenance - and we know labs like that!
Maintenance takes time and effort you don’t have to spare! With the Sysmex CA 660, maintenance requirements are low, and the system operates efficiently with little downtime. Integrated reagent cooling increases on-board reagent stability.

Cut down on human error
Automated sample identification ensures the right tests are performed on the right samples, and eliminates the need for sample batching. So the features you rely on with your more expensive analyzers are available in this refurbished unit too.
Smaller footprint. Bigger impact
The Sysmex CA 660 offers both short and long-term benefits to your lab, with:
- 25% less power consumption than most comparable analyzers
- Minimal consumables needed (only CA Clean I, CA Clean II, and reaction tubes)
- And only one reaction tube used per test
Reagents
Save 10% to 15% over your regular supplier when you order reagents from Block Scientific. Other suppliers use tiered pricing to give the biggest labs the biggest discounts because of their purchasing volume. We don’t do that. Instead, every customer and labs of every size get the same deals. It’s pricing 9 out of 10 labs couldn’t qualify for anywhere else.
Calibrators & Controls
With price-matching available, Block offers a selection calibrators to meet every laboratory need - all from leading manufacturers.
Financing options
Financing options are available for every Siemens System CA-660 purchase, so your small laboratory can be more prudent with expenses.
Service & repairs
Nation-wide, onsite service is available for new and used lab equipment purchased from Block Scientific or from the manufacturer. Block Scientific offers:
- Customized on-site annual service contracts
- Professional installation of all lab equipment and instrumentation
- Equipment familiarization following installation
- Time and material service visits, if equipment is not under our service contract
- Prompt and reliable service
- In-house service and repairs
- Depot service contracts (repairs conducted at Block Scientific facilities) covering all parts and labor, are offered for many smaller pieces of equipment such as centrifuges and small analyzers under 100 lbs
Technical Specifications
Dimensions
| 566 x 490 x 490 mm (W x D x H) |
| 22.5 x 19.5 x 19.5 in. |
Weight
| Approx. 43 kg/94.6 lb |
Method/channels
| Clotting/4, chromogenic,1 and immunologic1 |
Source Lamp
| Clotting | 4 LEDs with 660 nm/wavelength |
| Chromogenic | 1 LED with 405 nm/wavelength1 |
| Immunologic | 1 LED with 575 nm/wavelength1 |
Sample capacity
| 10 sample tubes |
Throughput (Approx)
| PT | 60 tests/hour |
| D-Dimer | 16 tests/hour |
| PT, APTT, Fibrinoogen | 48 simultaneous tests/hour |
| PT/APTT/Fibrinogen/AT | 40 simultaneous tests/hour |
| PT/APTT/Fib/D-Dimer | 32 simultaneous tests/hour |
Access mode
| Continuous random access (reaction tubes) |
Calibration
|
Automatic predefined calibration
|
STAT
| 1 priority position |
Reaction Tubes
| Single reaction tubes |
Reaction Tube Loading
| 60 reaction tubes onboard |
| automatic continuous access |
Assays
| PT | Thromborel® S Reagent, Dade® Innovin® Reagent |
| APTT | Dade Actin® Activated Cephaloplastin Reagent, Dade Actin FS Activated PTT Reagent, Dade Actin FSL ActivatedPTT Reagent, Pathromtin® SL Reagent |
| Fibrinogen | Multifibren® U Reagent, Dade Thrombin Reagent |
| Thrombin Time | Test Thrombin Reagent |
| Batroxobin Time | Batroxobin Reagent |
| Factor Deficiency | Coagulation Factor VII Deficient Plasma, Coagulation Factor VIII Deficient Plasma |
| Protein C Pathway | Protein C Reagent, Berichrom® Protein C |
| Heparin | Berichrom Heparin |
| Antithrombin | Berichrom Antithrombin III (A) Reagent, INNOVANCE® Antithrombin |
| D-Dimer | INNOVANCE D-Dimer |





